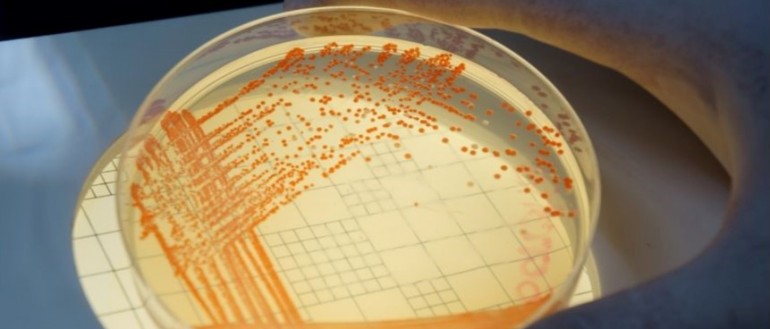
Impact of climate change on the spread of AMR

CRESTRA Masters opportunities
We currently have a PhD opportunity available for Master of Public Health or Master of Health Research students
CRESTRA Masters opportunities
We currently have a PhD opportunity available for Master of Public Health or Master of Health Research students
As one of Australia’s leading medical research institutes dedicated to improving the health and wellbeing of Aboriginal and Torres Strait Islander people, and a leader in global and tropical research into life-threatening illnesses, Menzies continues to translate its research into effective partnerships and programs in communities across Australia and the Asia-Pacific region. With a history of over 35 years of scientific discovery and public health achievement, Menzies continues its endeavour to break the cycle of disease and to reduce health inequities in Australia and the Asia- Pacific region, particularly for disadvantaged populations.
In partnership with Charles Darwin University, Menzies delivers high quality research degrees to PhD, Master by Research and Honours students. Our degrees address the major public health challenges in Northern and Central Australia, neighbouring and international regions. These challenges include: health inequities; economic and social determinants; changing environmental conditions; infectious and chronic diseases; development and urbanisation; and access to and acceptability of services. Our students are supported and mentored by world-class researchers in their respective research fields.
For more information regarding research project opportunities and to check your eligibility criteria please contact researchdegrees@menzies.edu.au.


.jpg&w=770&h=329)
.jpg&w=770&h=329)



.jpg&w=770&h=329)





.jpg&w=244&h=184)
.jpg&w=244&h=184)